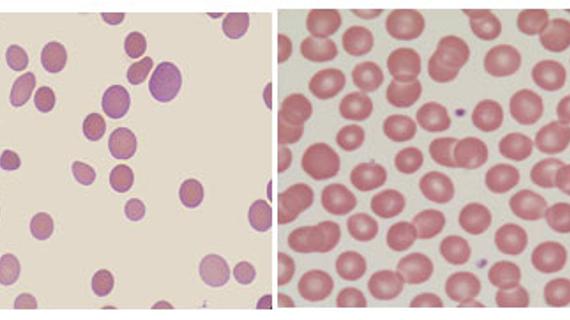

Взаимосвязь низкое давление и низкий гемоглобин
Гемоглобин – сложный белок, имеющий в составе железо и циркулирующий в крови человека внутри эритроцитов. Эго основной функцией является образование связи с кислородом и его перенос в...
Портал «Кардиограф» 
6ih3 
Первая помощь 
Журнал «Практическая медицина» 

6i5z 
Портал «Заболевания Нет» 
6igf 
6iga

Медицинская практика 


Простуда и грипп
Коронавирус
Гастроэнтерология
Заболевания легких и дыхательных путей
Заболевания печени
Заболевания горла
Заболевания вен и сосудов
Аллергология
Грибковые заболевания
Женские заболевания
Проктология
Кожные заболевания
Педиатрия
Заболевания суставов и костей
Заболевания спины и позвоночника
Беременность и роды
Заболевания сердца
Маммология
Онкология
Заболевания крови
Заболевания глаз
Красота
Диеты и здоровое питание
Заболевания ушей
Стоматология
Наркология
Косметология
Психиатрия
Сексология
Анализы и диагностика
Хирургия
Заболевания щитовидной железы 
Всё о печени 

Ортопед.ру 
Лечение заболеваний 
Ревматолог 

Про почки 
Мед. портал ОДС 
Портал «О болезнях дых.путей»